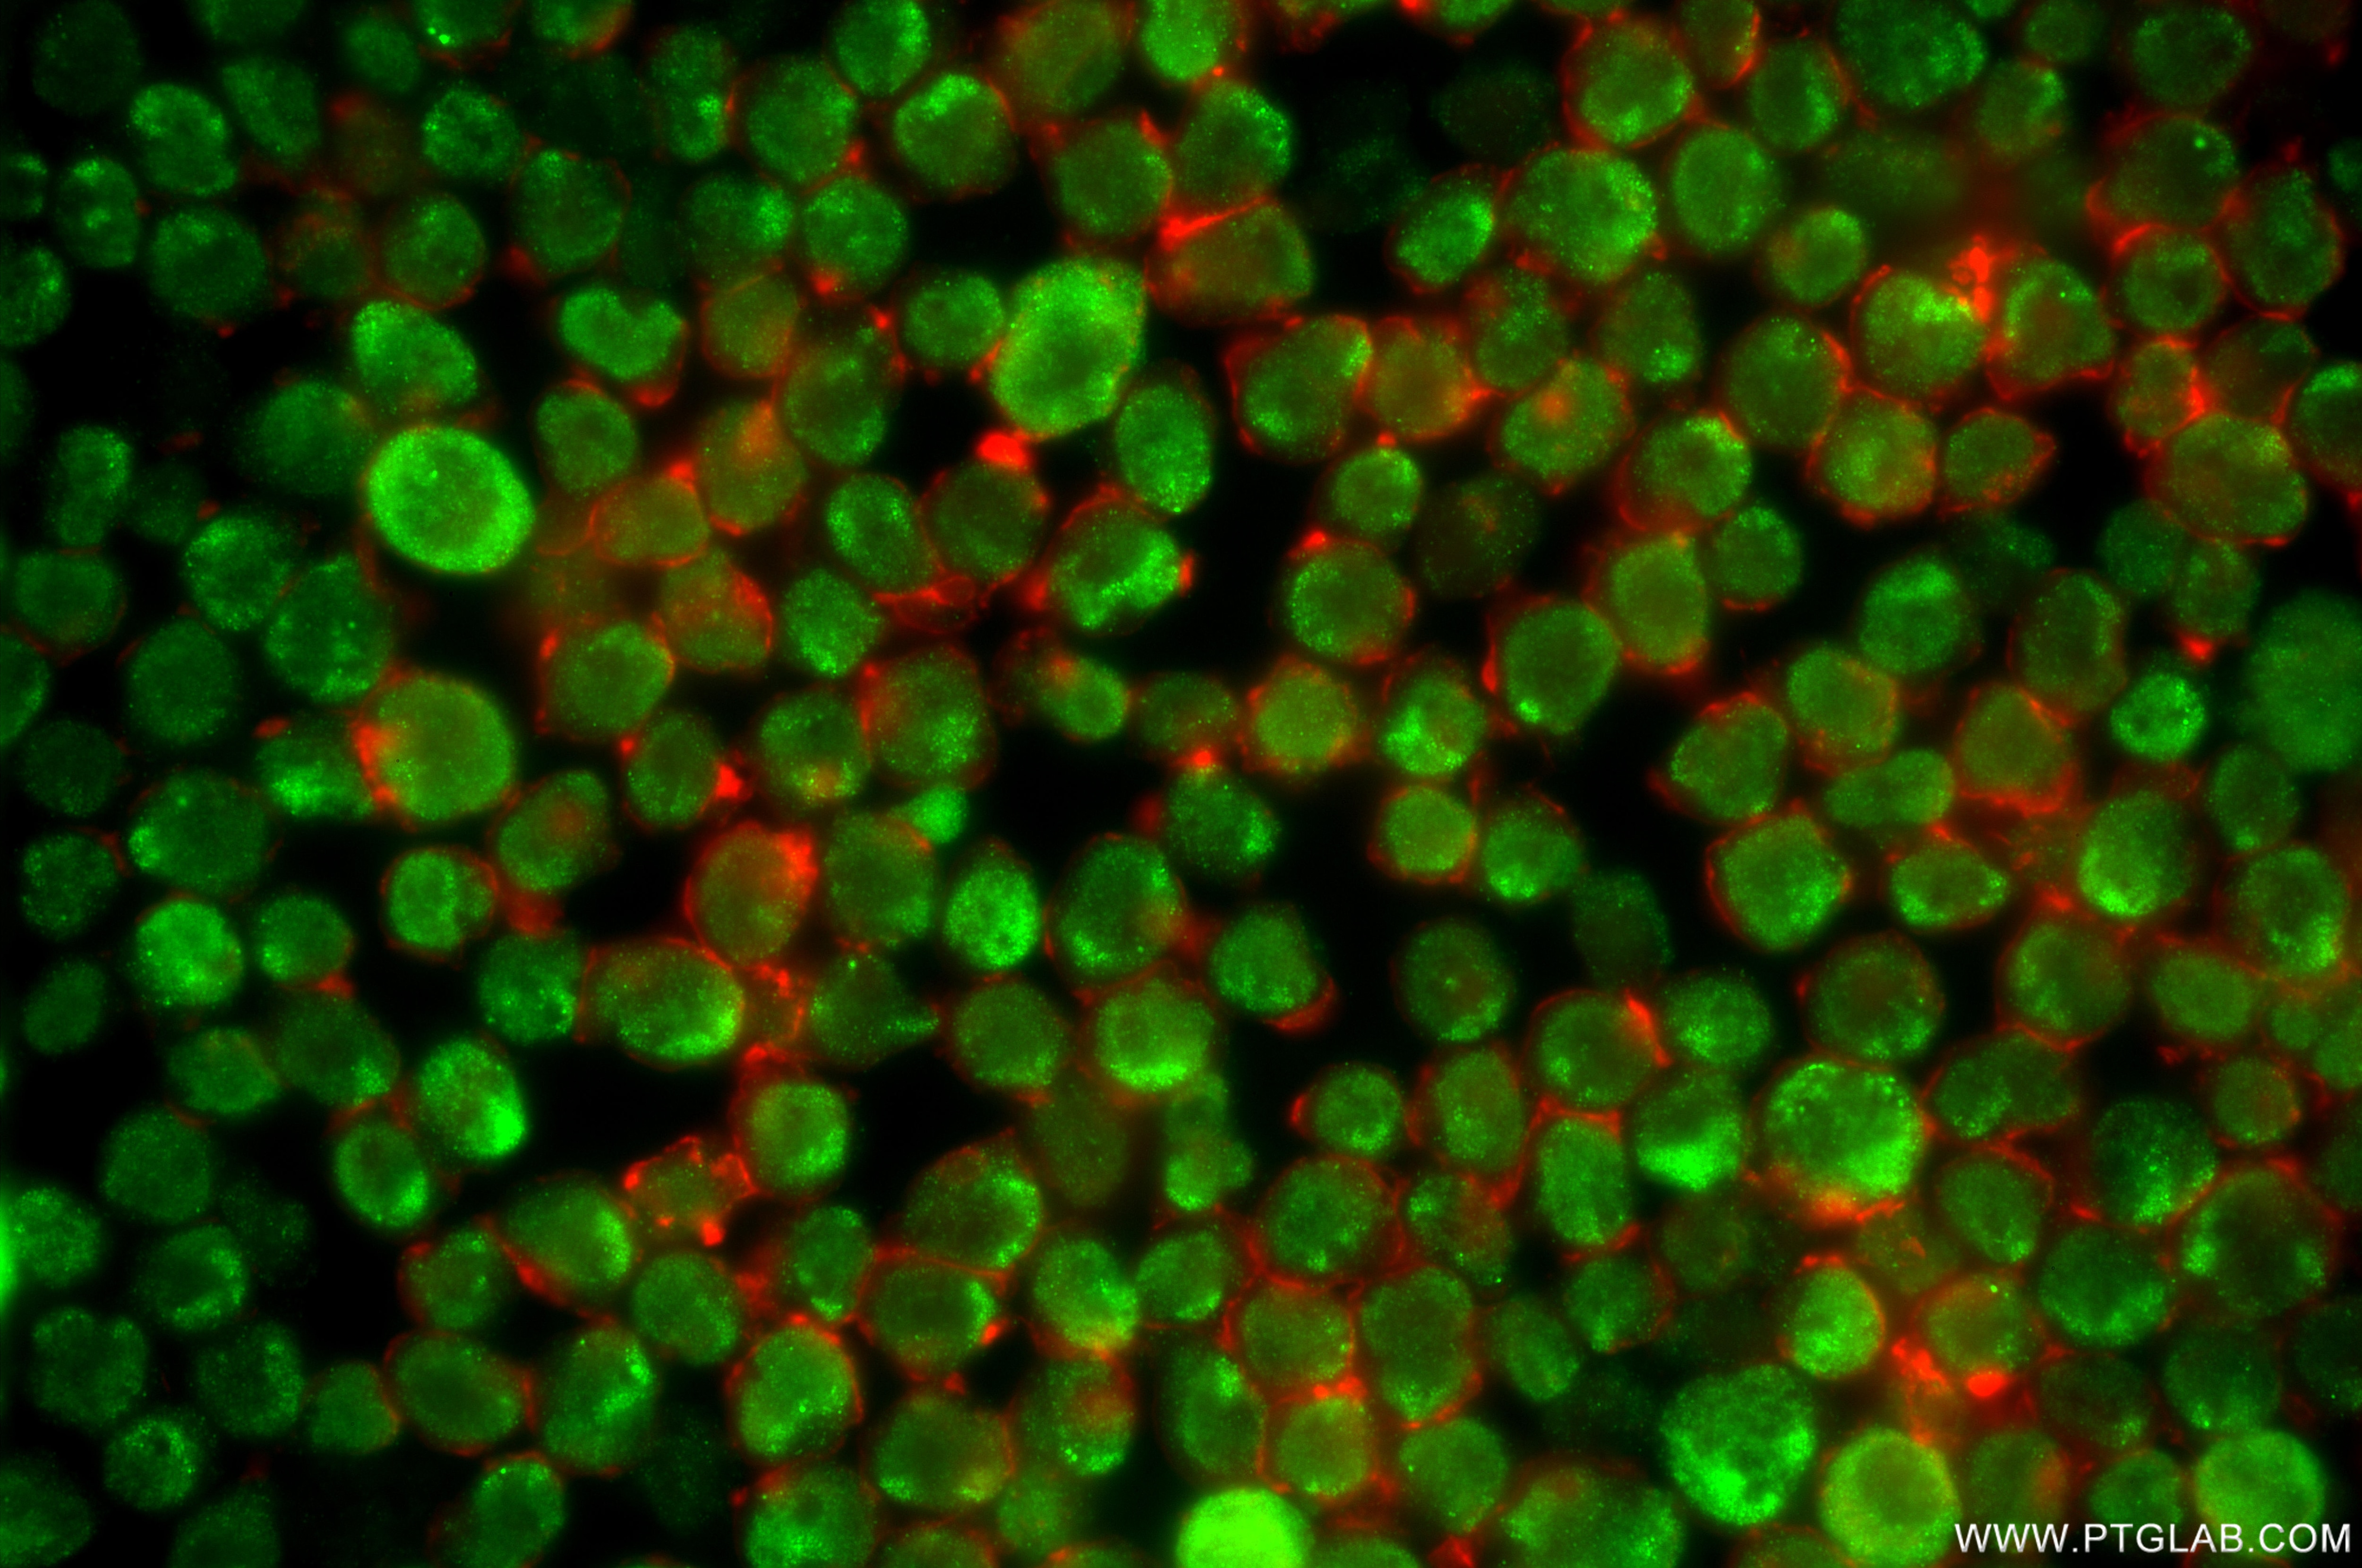
Immunofluorescence (IF) / fluorescent staining of Jurkat cells using TORC1/CRTC1 Recombinant monoclonal antibody (86226-3-RR)

Tested Applications
| Positive WB detected in | A431 cells, Jurkat cells, L02 cells, HeLa cells |
| Positive IF/ICC detected in | Jurkat cells |
Recommended dilution
| Application | Dilution |
|---|---|
| Western Blot (WB) | WB : 1:2000-1:10000 |
| Immunofluorescence (IF)/ICC | IF/ICC : 1:200-1:800 |
| It is recommended that this reagent should be titrated in each testing system to obtain optimal results. | |
| Sample-dependent, Check data in validation data gallery. | |
Product Information
86226-3-RR targets TORC1/CRTC1 in WB, IF/ICC, ELISA applications and shows reactivity with human samples.
| Tested Reactivity | human |
| Host / Isotype | Rabbit / IgG |
| Class | Recombinant |
| Type | Antibody |
| Immunogen |
CatNo: Ag0693 Product name: Recombinant human TORC1 protein Source: e coli.-derived, PGEX-4T Tag: GST Domain: 1-300 aa of BC028050 Sequence: MATSNNPRKFSEKIALHNQKQAEETAAFEEVMKDLSLTRAARLQLQKSQYLQLGPSRGQYYGGSLPNVNQIGSGTMDLPFQTPFQSSGLDTSRTTRHHGLVDRVYRERGRLGSPHRRPLSVDKHGRQADSCPYGTMYLSPPADTSWRRTNSDSALHQSTMTPTQPESFSSGSQDVHQKRVLLLTVPGMEETTSEADKNLSKQAWDTKKTGSRPKSCEVPGINIFPSADQENTTALIPATHNTGGSLPDLTNIHFPSPLPTPLDPEEPTFPALSSSSSTGNLAANLTHLGIGGAGQGMSTP Predict reactive species |
| Full Name | CREB regulated transcription coactivator 1 |
| Calculated Molecular Weight | 75 kDa |
| Observed Molecular Weight | 68-80 kDa |
| GenBank Accession Number | BC028050 |
| Gene Symbol | CRTC1 |
| Gene ID (NCBI) | 23373 |
| Conjugate | Unconjugated |
| Form | Liquid |
| Purification Method | Protein A purification |
| UNIPROT ID | Q6UUV9 |
| Storage Buffer | PBS with 0.02% sodium azide and 50% glycerol, pH 7.3. |
| Storage Conditions | Store at -20°C. Stable for one year after shipment. Aliquoting is unnecessary for -20oC storage. 20ul sizes contain 0.1% BSA. |
Background Information
CRTC1, also named as MECT1,TORC1, and WAMTP1, belongs to the TORC family. It is a transcriptional coactivator for CREB1 which activates transcription through both consensus and variant cAMP response element (CRE) sites. CRTC1 acts as a coactivator, in the SIK/TORC signaling pathway, being active when dephosphorylated and acts independently of CREB1 'Ser-133' phosphorylation. It enhances the interaction of CREB1 with TAF4. CRTC1 regulates the expression of specific CREB-activated genes such as the steroidogenic gene, StAR. It is a potent coactivator of PGC1alpha and inducer of mitochondrial biogenesis in muscle cells. CRTC1 is also a coactivator for TAX activation of the human T-cell leukemia virus type 1 (HTLV-1) long terminal repeats (LTR). In the hippocampus, CRTC1 involved in late-phase long-term potentiation (L-LTP) maintenance at the Schaffer collateral-CA1 synapses. It may be required for dendritic growth of developing cortical neurons. CRTC1 has some isoforms produced by alternative splicing with MW of 67 kDa, 68 kDa and 62 kDa. Sometimes it appears as a 75-80 kDa band probably due to phosphorylation (PMID: 17183642; 22770221)
Protocols
| Product Specific Protocols | |
|---|---|
| IF protocol for TORC1/CRTC1 antibody 86226-3-RR | Download protocol |
| WB protocol for TORC1/CRTC1 antibody 86226-3-RR | Download protocol |
| Standard Protocols | |
|---|---|
| Click here to view our Standard Protocols |